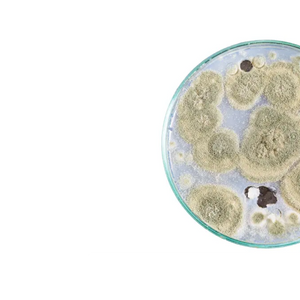

Mehr als 175.000 Kunden vertrauen uns. Kostenloser Versand für alle Produkte.
























Für ein gesundes Gleichgewicht von innen

100% Zufriedenheitsgarantie

Kostenloser Versand

+175.000 Kunden

 Wir sind überzeugt, dass Ihnen unsere Produkte gefallen werden! Sollten Sie jedoch mit einem Produkt nicht vollständig zufrieden sein, können Sie es innerhalb von 60 Tagen nach dem Kauf zurückgeben oder umtauschen.
Wir sind überzeugt, dass Ihnen unsere Produkte gefallen werden! Sollten Sie jedoch mit einem Produkt nicht vollständig zufrieden sein, können Sie es innerhalb von 60 Tagen nach dem Kauf zurückgeben oder umtauschen.
 Vegan
Vegan
 Glutenfrei
Glutenfrei
 Zuckerfrei
Zuckerfrei
 Hefefrei
Hefefrei
 Laktosefrei
Laktosefrei
 Gelatinefrei
Gelatinefrei
 GVO-frei
GVO-frei
 Frei von Süßstoffen
Frei von Süßstoffen
 Frei von künstlichen Farbstoffen
Frei von künstlichen Farbstoffen
 Frei von Geschmacksstoffen
Frei von Geschmacksstoffen
 Frei von Konservierungsmitteln
Frei von Konservierungsmitteln
Unterstützt eine gesunde Verdauung
Hilft bei der Aufnahme von Nährstoffen
Für eine gesunde Darmflora
Unterstützt das Immunsystem
Unterstützt das Gleichgewicht guter Bakterien in deinem Darm
Trägt zu einem normalen Energieniveau bei
Vegan





Unterstützt eine gesunde Verdauung
Die 7 sorgfältig ausgewählten Bakterienstämme in unseren Probiotika, wie Lactobacillus acidophilus und Bifidobacterium bifidum, tragen zu einer normal funktionierenden Verdauung bei.

Hilft bei der Aufnahme von Nährstoffen
Unsere Formel enthält Bakterienstämme, die zur normalen Aufnahme von Nährstoffen beitragen, wie B-Vitamine, um dein Energieniveau zu unterstützen.

Fördert eine gesunde Darmflora
Eine ausgewogene Darmflora ist essentiell für dein allgemeines Wohlbefinden. Unsere Probiotika unterstützen das Gleichgewicht guter Bakterien im Darm.

Unterstützt das Immunsystem
Eine gesunde Darmflora trägt zur normalen Funktion deines Immunsystems bei, was wichtig für deine natürliche Abwehr ist.
"Weg mit Völlegefühl und Bauchschmerzen. Was für ein super Produkt!"
Connie
Bio-Inulin
Eine pflanzliche Faser, die als Nahrung für gute Darmbakterien dient.

Bakterienstämme
Eine sorgfältig ausgewählte Mischung aus lebenden Bakterienkulturen, 7 Bakterienstämme
Bio-Baobab
Ein ballaststoffreiches Fruchtpulver, das die Darmflora unterstützt.

Vegane Kapsel
HPMC-Kapsel. Eine pflanzliche, magensaftresistente Kapsel, die den Inhalt schützt.

Eine Dose Probiotica enthält 60 pflanzliche Kapseln. Anwendung: Täglich 2 Kapseln vor oder zum Frühstück einnehmen. Die empfohlene Dosis nicht überschreiten.
| RI* |
|
| Probiotica: 4,5 Milliarden - Bifidobacterium bidifum -BBi32 - Bifidobacterium longum-BL21 - Lactobacillus acidophilus-LA85 - Lactobacillus casei-LC89 - Lactobacillus helveticus-LH76 - Lactobacillus rhamnosus-LRa05 - Lactobacillus plantarum)-Lp90 |
45 mg |
| Bio-Inulin |
382 mg |
| Bio-Baobab |
22 mg |
* Referenzmenge
Zutaten pro Kapsel: Bio-Inulin, Bakterienstämme, Bio-Baobab-Fruchtpulver, vegane Kapsel: HPMC (magensaftresistent)
Enthält keine: GVO, Gluten, künstliche Farbstoffe, Aromen oder Konservierungsstoffe
Anwendung: Nehmen Sie täglich 2 Kapseln vor oder während des Frühstücks ein. Überschreiten Sie nicht die empfohlene Dosis.
Aufbewahrung: Trocken und bei Raumtemperatur (15°C–25°C) lagern. Außerhalb der Reichweite und Sichtweite von kleinen Kindern aufbewahren.
Nahrungsergänzungsmittel: Eine gesunde Lebensweise ist wichtig, ebenso wie eine abwechslungsreiche und ausgewogene Ernährung, die Nahrungsergänzungsmittel nicht ersetzen können.
 Schritt 1
Nehmen Sie 2 Kapseln pro Tag mit einem Glas Wasser vor oder während Ihres Frühstücks. Die empfohlene Dosierung nicht überschreiten.
Schritt 1
Nehmen Sie 2 Kapseln pro Tag mit einem Glas Wasser vor oder während Ihres Frühstücks. Die empfohlene Dosierung nicht überschreiten.




Unsere Mission besteht darin, Ressourcen bereitzustellen, um unseren Planeten wiederherzustellen, ein Produkt nach dem anderen.

Nutrianer sind klimabewusste Menschen, denen ihre geistige und körperliche Gesundheit am Herzen liegt. Sie entscheiden sich für Nutrifoodz aufgrund der Regreen-Revolution und unserer Expertise in veganer und gesunder Ernährung.
Nutrifoodz versteht die Bedürfnisse, denen wir als Gesellschaft im Alltag gegenüberstehen. Wir sind uns jedoch nicht einig, wie diese Bedürfnisse erfüllt werden. Die Art und Weise, wie wir uns selbst, unsere Tiere und unseren Planeten behandeln, ist unfassbar. Sie können etwas dagegen tun! Gemeinsam können wir dazu beitragen, die Welt, in der wir leben, zu verbessern.

Von Drittanbietern getestet
Nutrifoodz®-Produkte werden in einem unabhängigen wissenschaftlichen Labor getestet, um Qualität und Wirksamkeit sicherzustellen.

Schwermetallgeprüft
Sie können mit absoluter Sicherheit davon ausgehen, dass alle Inhaltsstoffe mit erstklassigen Testmethoden auf Schwermetalle getestet wurden.

Frei von künstlichen Zusatzstoffen
Frei von künstlichen Füllstoffen, Konservierungsmitteln, künstlichen Süßstoffen, Bindemitteln und anderen Zusatzstoffen, die Ihr Körper nicht braucht …
Nutzen Sie unser einfaches 2-Minuten-Quiz, um herauszufinden, welches Produkt am besten zu Ihren Anforderungen passt. Es ist völlig kostenlos und schnell!
Starten Sie Ihren Vitamin-TestSie profitieren stets von kostenlosem Versand für alle Ihre Bestellungen.
Gemeinsam haben wir bereits über 8.000.000 m² begrünt!
Entdecken Sie alle Vorteile, von denen so viele Nutriens begeistert sind
Nicht zufrieden? Rücksendungen sind immer problemlos!